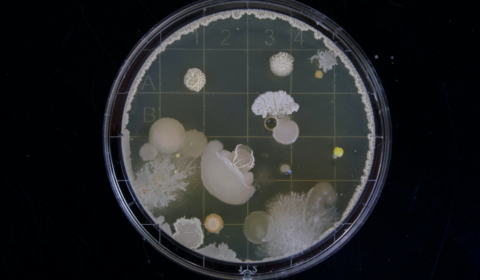
Pathogenic fungi could get stronger as the climate grows warmer

Latest Stories from Jessica
This tree offers an eco-friendly alternative to palm oil and soy
Farmers in Hawaii are cultivating the pongamia, a tree that could prevent further clearing of natural rainforests for palm oil and soy plantations. Its resilient nature could offer a huge economic boost to farmers losing out due to land degradation. Palm oil is known as one of the most environmentally destructive, yet common and easy-to-miss ingredients in food products today. This elusive and pervasive ingredient has led to the deforestation of...
Florida lawmakers look to ban ‘period talk’ in local schools
Mere months before discussions about sexual orientation become prohibited in state-wide Florida schools, Republicans are now looking to do the same for lessons and discussions about menstruation. Republicans in Florida have been on a mad one for quite some time. Last year, they passed the Don’t Say Gay bill, which will ban school staff and pupils from leading or discussing any conversations about sexual orientation before they enter grade four. Considering an...
Should fossil fuel firms be charged with homicide?
Legal experts are preparing to publish a paper in next year’s Harvard Environmental Law Review. They will argue that fossil fuel companies should be charged with homicide for the deaths they’ve caused by accelerating the climate crisis. The booming fossil fuel industry continues to be the number one cause of the worsening environmental crisis. Individuals running these companies have been aware of their actions' consequences for decades, yet have shown no...
Mounting reports confirm Gen Z favours fake luxury fashion
Several reports have indicated that Gen Z is not opposed to buying counterfeit luxury fashion items despite being branded as the most eco-conscious generation yet. While we know Gen Z is by far the most clued up and vocal about environmental issues, mounting reports suggest that this age group’s habits don’t always reflect their concerns – especially when it comes to obtaining 'high' fashion. The counterfeit luxury fashion industry has been...
These four initiatives are boosting Britain’s re-wilding agenda
Since the start of the industrial revolution, the UK has lost nearly half of its total biodiversity – more than any other G7 nation. Hundreds of local organisations have launched projects to protect and rewild British landscapes. Let's take a look at a few of them. In 2021, scientists at London’s Natural History Museum conducted a huge study to assess the health of Britain’s biodiversity. What they found was that over...
The ICC issues arrest warrant for Vladimir Putin over war crimes
A little over a year has passed since Russia first invaded Ukraine. Now the International Criminal Court has issued an arrest warrant for Vladimir Putin for his alleged war crimes. The international criminal court has just issued arrest warrants for Vladimir Putin and his children’s rights commissioner, Maria Alekseyevna Lvova-Belova. Both leading parties have been accused of the unlawful deportation of Ukrainian children throughout the war, which has been going on...
Bermuda is on a mission to expand its marine conservation laws
Through consultation with residents and local fishermen, Bermuda is looking to expand its ocean conservation efforts. Named The Blue Prosperity Plan, the project will attract global investors to its Blue Economic Zone in exchange for protecting its vibrant marine habitats. The island of Bermuda is often referred to as the ‘jewel of the Atlantic,’ and for good reason. Though commonly mistaken as part of the Caribbean, Bermuda is located in complete...
Pathogenic fungi could get stronger as the climate grows warmer
While mushrooms may now be helping combat depression, not all fungi are friends. Evolved types, such as pathogenic fungi, pose a threat to human health and studies warn that climate change could increase their potency. We’ve been warned time and time again about the human health risks posed by a warmer climate. Fighting off infection, reducing the spread of viruses, and stopping novel and dangerous pathogens from travelling between animals and...
Can made-to-order clothing brands slow our fashion consumption?
In the last few decades, we’ve fallen into a vortex of quick consumption and rapid throwaway when it comes to fashion items. As vintage shopping and rental services gain widespread popularity, could slowing down the production of fashion altogether be next? Inside global warehouses, an unthinkable number of clothing items sit on shelves waiting to be purchased. With fast fashion brands dominating the market and producing thousands of identical styles, the...
WhatsApp could end UK services over upcoming Online Safety Bill
The UK’s Online Safety Bill is due to come into effect by the end of this year, but its rules conflict with WhatsApp’s end-to-end encryption feature. The messaging app’s leaders are refusing to weaken their privacy standards when 98 percent of its users are located elsewhere. For most users of the platform, WhatsApp’s end-to-end encryption feature is a benefit. It acts as a guaranteed layer of security, ensuring that only those...